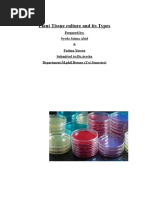

0% found this document useful (0 votes)
21 views6 pagesChapter 8 Pharmaceutics
Chapter 8 discusses liquid dosage forms, highlighting their advantages such as flexibility in dosing and faster absorption, as well as disadvantages like bulkiness and stability concerns. It covers excipients used in formulations, including sweeteners, viscosity-controlling agents, buffers, antioxidants, flavoring agents, and preservatives, which enhance stability and patient acceptability. Additionally, it details solubility enhancement techniques, both physical and chemical, to improve the therapeutic efficacy and bioavailability of drugs.
Uploaded by
mdtajaliansari786192Copyright
© © All Rights Reserved
We take content rights seriously. If you suspect this is your content, claim it here.
Available Formats
Download as PDF, TXT or read online on Scribd
0% found this document useful (0 votes)
21 views6 pagesChapter 8 Pharmaceutics
Chapter 8 discusses liquid dosage forms, highlighting their advantages such as flexibility in dosing and faster absorption, as well as disadvantages like bulkiness and stability concerns. It covers excipients used in formulations, including sweeteners, viscosity-controlling agents, buffers, antioxidants, flavoring agents, and preservatives, which enhance stability and patient acceptability. Additionally, it details solubility enhancement techniques, both physical and chemical, to improve the therapeutic efficacy and bioavailability of drugs.
Uploaded by
mdtajaliansari786192Copyright
© © All Rights Reserved
We take content rights seriously. If you suspect this is your content, claim it here.
Available Formats
Download as PDF, TXT or read online on Scribd